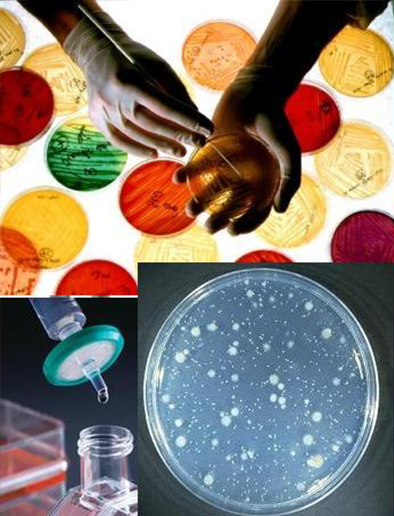

Laboratorio de Análisis Microbiológicos
MicroBioBase Laboratorio Cía. Ltda., tienen como finalidad, poner al servicio de clientes e industrias, análisis en el campo de la Microbiología, brindando resultados confiables, rápidos y de calidad, realizados por personal calificado y ejecutados bajo normativas nacionales e internacionales.

MicroBioBase Laboratorio, se encuentra acreditado por el Servicio de Acreditación Ecuatoriana (SAE), bajo la Norma NTE INEN-ISO/ IEC 17025 “Requisitos Generales para la competencia de los laboratorios de Ensayo y Calibración”.
- Es un laboratorio que realiza análisis Microbiológicos, con énfasis en la microbiología alimentaria, en productos terminados, materias primas e insumos.
- Control de la calidad en procesos industriales en el área de la microbiología sanitaria, para la validación de procesos de BPM:
o Análisis de superficies de utensilios, equipos, entre otros.
o Análisis de superficies vivas (manipuladores de alimentos).
o Ambientes.
o Validación de productos de desinfección y limpieza.
Realiza control de calidad en procesos industriales en el área de la microbiología sanitaria: análisis de superficies, manipuladores (personal) y ambientes.
Microbiología agrícola y microbiología relacionada a procesos industriales en general.
La Gerencia se compromete a establecer, implementar y mantener el Sistema de Gestión basándose en la Norma ISO IEC 17025, con el objetivo de satisfacer las necesidades analíticas del cliente, para lo cual involucra a todo el personal en el conocimiento de la política y el manejo del Sistema de Gestión de la Calidad, para apoyar al mejoramiento continuo y disponer de personal calificado que garanticen la calidad de los resultados, además de participar en rondas de intercomparaciones con el fin de garantizar un servicio de calidad.
La Gerencia proporcionará los recursos necesarios para la correcta ejecución de los análisis realizados, los mismos que cumplirán con las normas nacionales e internacionales.
La Gerencia establecerá las bases, para que las actividades analíticas, no compromentan el juicio técnico de los análisis de ensayo.
MicroBioBase Laboratorio, ofrece los siguientes servicios:
Con los mejores standares y seguridad
Control de calidad en procesos industriales - validación de procesos para BPM

Determinación de la calidad de los ingredientes y los productos terminados
Tanto a personal de empresa como a supervisores en general.
En implementación y ejecución de procesos.
Servicios de capacitación, asesorías, asistencia técnica en proyectos relacionados al campo de la Microbiología.
Nuestro laboratorio, nuestro equipo.
Copyright © 2016 MicroBioBase Web By CutchiStudios